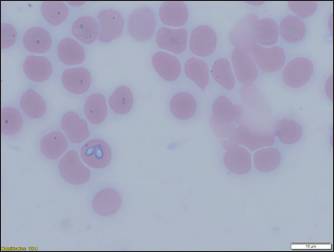
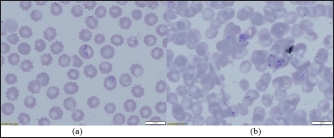
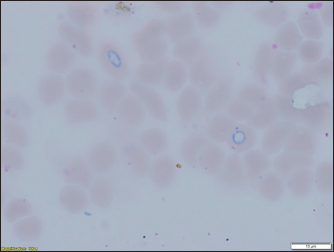

| Research Article | ||
Open Vet. J.. 2023; 13(9): 1184-1194 Open Veterinary Journal, (2023), Vol. 13(9): 1184–1194 Original Research Identification of the causative agent of canine babesiosis in the North of KazakhstanAigul Zhabykpayeva1, Lyubov Kulakova1, Raushan Rychshanova2*, Kulyay Suleimanova3 and Alexandr Shevtsov41Department of Veterinary Medicine, A. Baitursynov Kostanay Regional University, Kostanay, Republic of Kazakhstan 2Research Institute of Applied Biotechnology, A. Baitursynov Kostanay Regional University, Kostanay, Republic of Kazakhstan 3Department of Natural Sciences, Z. Aldamzhar Kostanay Social-Technical University, Kostanay, Republic of Kazakhstan 4Applied Genetics Laboratory, National Center for Biotechnology, Astana, Republic of Kazakhstan *Corresponding Author: Raushan Rychshanova. Research Institute of Applied Biotechnology, A. Baitursynov Kostanay Regional University, Kostanay, Republic of Kazakhstan. Email: rychshanovaraushan [at] gmail.com Submitted: 01/05/2023 Accepted: 29/08/2023 Published: 30/09/2023 © 2023 Open Veterinary Journal
AbstractBackground: Canine babesiosis is a common disease in the northern part of the Republic of Kazakhstan, in particular in the Kostanay region. In recent years, a large number of cases of the disease with a variety of clinical symptoms have been registered. Aim: The purpose of the study was to monitor the spread, characterization, and identify the Babesia species involved of Babesia species in ticks and blood of dogs in the Kostanai region. Methods: The research work began in 2017 with the study of the spread of babesiosis in dogs in the Kostanay region according to the reports of veterinary clinics. The collection of ticks from the territory and from dogs was carried out in 2017–2021. Results: As a result of the research work, the presence in the city and some areas of the Kostanay region of two species of ixodid Dermacentor reticulatus and Dermacentor marginatus, was established. Of these, one species was identified in dogs, which serves as a carrier of canine babesiosis—D. reticulatus. In all 31 DNA samples from the blood of dogs diagnosed with babesiosis, a fragment of the 18S rRNA gene was amplified. The nucleotide sequence was obtained for 30 samples (96.8%), in one sample a low luminescence intensity of a specific PCR product was observed. Two Babesia canis haplotypes were distinguished on the basis of two nucleotide substitutions (GA→AG) observed in the sequences of the 18S rRNA gene. Conclusions: In conclusion, the results of this study provide insight into the distribution of B. canis haplotypes in dogs in the Kostanay region, and canine babesiosis is caused solely by the large Babesia species B. canis. Keywords: Babesia canis, Dermacentor reticulatus, Disease monitoring, Molecular typing. IntroductionIxodid ticks are found in all climatic zones of the world, but the greatest diversity of species is found in tropical and subtropical countries. More than half of all species of ticks known in the Commonwealth of Independent States are common in Kazakhstan. About a third of all species approach the territory of Kazakhstan with their range, and it is likely that many of these species are present in Kazakhstan, although they are not currently defined everywhere (Domatsky and Aubakirov, 2015). The geographical location of Kazakhstan, bordering on the known natural foci of blood-parasitic infections located on the territory of the Russian Federation, the variety of landscape and climatic conditions and the animal world create favorable conditions for the circulation of carriers of canine babesiosis in north region (Livanova et al., 2018). On the territory of Kazakhstan and Russia, there are ticks belonging to six genera: Boophilus, Dermacentor, Haemaphysalis, Hyalomma, Ixodes, and Rhipicephalus (Domatsky and Aubakirov, 2015). Ixodid ticks are the vectors of many animal diseases and carry human pathogens: the virus of tick-borne encephalitis, and bacteria causing tick-borne borreliosis (Lyme disease), typhus, recurrent tick-borne typhus, hemorrhagic fever, Q fever, tularemia, and many others, as well as pathogens of piroplasmosis. Babesiosis is one of the main vector-borne diseases of dogs worldwide (del Mar Fernández de Marco et al., 2017), the causative agent of infection in various species of the hemoprotozoan genus Babesia, carried by ticks (Boozer and Macintire, 2003; Köster et al., 2015). However, in the modern world, the existence of exclusively synanthropic foci of the disease is noted (Belimenko et al., 2012). The intensification of anthropogenic transformation of nature leads to a change in the living conditions of pathogens of blood parasitic diseases and their biological vectors in the environment. This has affected the increase of vector-borne animal diseases transmitted by ixodid ticks (Malkova, 2011; Shabdarbayeva and Balgimbayeva, 2011). Domestic and wild dogs are infected with several species of Babesia, which can cause serious diseases. Over the past 30 years, several species of Babesia spp. have been identified as pathogenic to dogs, which have been described in detail and genetically characterized (Solano-Gallego and Baneth, 2011). Babesia was originally classified according to the morphology of the parasite in erythrocytes as “large” and “small” forms, recognizable as Babesia canis and Babesia gibsoni (Köster et al., 2015). Genetic analysis also showed that there were several smaller species of Babesia spp. which are genotypically distinct from B. gibsoni. These include Babesia conradae and Babesia annae (Baneth et al., 2019), Babesia microti-like Babesia (Zahler et al., 2000), “Babesia Spanish dog isolate” (Yeagley et al., 2009), “B. annae” (Camacho et al., 2005), “Babesia (Theileria) annae” (Clancey et al., 2010) and “B. microti,” which occur in separate lines or cells (Schnittger et al., 2012; Lack et al., 2012). The highly pathogenic Babesia rossi is transmitted by Haemaphysalis elliptica (formerly H. leachi) in South Africa, while the low pathogenic Babesia vogeli is transmitted by Rhipicephalus sanguineus, mainly in tropical and subtropical zones, a South European species found in a number of regions of the Russian Federation. Babesia canis is transmitted by Dermacentor reticulatus in Europe and Russia, and often are vectors of severe diseases (Cacciò et al., 2002; Duh et al., 2004; Rar et al., 2006; Livanova et al., 2018). Babesia gibsoni mainly occurs in Asia, including Japan, and is transmitted by. Haemaphysalis longicornis occurs in Asia, including Japan, with a worldwide distribution (Irwin, 2009). Amblyomma aureolatum is involved in the transmission of Rangelia vitalii. On the territory of the Republic of Kazakhstan, despite the relevance of the problem and the presence of natural-climatic, biological, and epizootological prerequisites for the existence of ixodid ticks as carriers of canine babesiosis, little scientific attention is paid to this disease of dogs. Therefore, there is little information on the incidence of blood parasitic diseases in dogs in the Kazakh literature. In some regions of the country, which often represent foci of the habitat of hemoprotozoan vector ticks, information on the spread of babesiosis is often not available. There are single data on this disease in the southeastern zone of Kazakhstan (Shabdarbayeva and Balgimbayeva, 2008). Unfortunately, data on canine babesiosis and genetic characteristics of Babesia species in dogs were not found in the northern region of Kazakhstan and studies were conducted on the incidence of dogs with babesiosis in the Kostanay region. This study aimed to monitor the spread, characterize, and identify the causative agent of canine babesiosis in ticks and blood of dogs in the Kostanay region. Materials and MethodsTick collection and identificationFrom May to October 2017–2019, adults of ixodid ticks on the territory of the northwestern part Kostanay region Republic of Kazakhstan, bordering the Russian Federation, were collected. Ticks were collected during the period of tick activity with a fluffy white cloth blanket (60 × 100 cm) using both dragging and flagging techniques, on the ground and the bushes. Ticks were removed from the blanket with tweezers and placed in plastic test tubes. Between May 2018 and October 2021, ticks were collected from dogs in veterinary diagnostic centers and veterinary clinics in the Kostanay region. Determination of the type of ticks was carried out in the laboratory of the Department of Veterinary Medicine of A. Baitursynov Kostanay Regional University with confirmation of identification at the National University of Bioresources and Environmental Management of Ukraine at the Department of Veterinary Parasitology and Tropical Veterinary Medicine. Babesia detection and analysisBabesia was detected by thin blood smears taken from the ear veins of dogs. The smears were fixed for 3 minutes in methanol, stained in Romanovsky-Giemsa solution for 25 minutes, washed with distilled water, and examined under light microscopy at 1000× magnification using oil immersion. Samples were considered positive when single trophozoites and/or paired pear-shaped merozoites of Babesia sp. were detected in erythrocytes. To carry out morphometry of the parasite, positive samples were selected for comparative size measurement with an Olympus microscope, using Olympus DP72 digital cameras and cellSens V3.2. (2022) at the Lithuanian University of Health Sciences, Kaunas, Lithuania. Frozen ticks were individually packaged in tubes and homogenized in 500 μl physiological saline solution (MagNALyser Instrument, Roche Diagnostics, Switzerland). The homogenate was allowed to settle for 30 minutes, and DNA was isolated from 200 μl of the supernatant using the PROBA-NK/PROBA-NK-PLUS kit (DNA Technology, Russia) in accordance with the manufacturer’s instructions. Before the study, the samples were stored at 80°C. Genetic analysis and phylogeneticsDNA isolated from ticks was examined for the presence of Babesia DNA using the two-round PCR method in the presence of genus-specific primers from the region of the 18S rRNA gene fragment 344–383 bp long for different species. All PCR reactions were carried out in 20 μl of a reaction mixture containing 67 mM Tris-HCl (pH 8.9), 16.6 mM (NH4) 2SO4, 2 mM MgCl2, 0.01% Twin 20, 200 mM of each dNTP, 5% glycerin, 0.02% cresol red, 5′ bp, 2 DNA Taq polymerase and 2 μl purified DNA for primary reactions or 2 μl primary PCR products for nested reactions. During the first round of PCR, BS1 primers (gacggtagggtattggcct) 58°C were used (Rar et al., 2005) and BS2 (attcaccggatcactcgatc), the reaction was carried out under the following conditions: 94°C for 4 minutes; 35 amplification cycles 94°C for 1 minute, 55°C for 1 minute, 72°C for 1.5 minutes. During the second round of PCR, aliquots were added 2 μl of DNA from the PCR of the first round. in the presence of primers specific to true Babesia sensu stricta (primers BS5 (cgaggcagcaacgggtaacg) 60°N BS4 (agggacgtagtcggcacgag)), under the following conditions 94°C for 1 minute; 35 cycles, 94°C for 1 minute 60°C for 1 min, 72°C for 1.5 min. Electrophoresis of PCR products of the first and second stages was carried out in 1% agarose with SYBRgreen. The species and genetic variants were determined by determining the nucleotide sequences of purified PCR products. PCR products were purified (GFX Columns, Amersham Biosciences, USA) sequenced (ABI 3500 Genetic Analyzer, Applied Biosystems, USA), aligned (BioEdit v7.2.5, Ibis Biosciences, USA) and analyzed by BLAST 2.13.0+ (2022) and Clustal W 2.0.12 (2012) at the Institute of Chemical Biology and Fundamental Medicine, SB RAS Novosibirsk, Russia. Blood samples from 31 dogs diagnosed with babesiosis were collected in micro-samples for PCR studies with ethylenediaminetetraacetic acid (volume 0.5 ml). Blood was collected from the plantar vein from May to October in 2019, 2020, and 2021 in the city of Kostanay and Kostanay region. DNA was isolated from 200 μl with a SAMPLE-NK/SAMPLE-NK-PLUS kit (DNA Technology, Russia). Detection of Babesia in the blood of dogs was carried out according to the protocol proposed by Hilpertshauser et al. (2007), followed by sequencing of PCR products. Phylogenetic trees were constructed using MegaX software (Kumar et al., 2004). Ethical approvalThis study was conducted in compliance with the principles of ethical research involving animals, as outlined in the Guidelines for the Care and Use of Laboratory Animals of the National Institutes of Health. All animal procedures were approved by the Institutional Animal Care and Use Committee. The collection of ticks from the environment and from dogs was carried out with the consent of the owners and in accordance with the guidelines of the National Veterinary Association. The blood samples from dogs were collected with the informed consent of their owners and in accordance with the guidelines for the ethical treatment of animals. The data obtained from this study will be used solely for scientific purposes and will be reported in a manner that respects the confidentiality and privacy of the dogs and their owners. ResultsA total of 681 specimens of ixodid ticks were collected in the field. In the territory of Kostanay region, in particular, Fedorovsky, Auliekolsky, Mendykarinsky, Karabalyksky, Kostanay, and Zhitikarinsky districts, 427 ticks were collected, 254 of them in the city of Kostanay (Table 1). From May to October 2018–2021, 119 dogs were examined for the presence of ticks in veterinary clinics of Kostanay. In total, 78 ixodid ticks that were engorged or semi-engorged with blood were removed from 31 dogs. All removed ticks were identified as D. reticulatus. Table 1. Ixode ticks collected from the surface of the body of dogs and on the territory of Kostanay region.
The density of ticks in the city is much lower than in the suburbs. In Kostanay, in the season of tick activity, two peaks of dog infestation with ticks were observed: in spring in April–May and in autumn at the end of August to October (Fig. 1). The appearance of the first active ticks was noted after the melting of snow, according to this research and the average statistical temperature in 2017—March 24, in 2018–2021—April 5. Two species of ticks, D. marginatus (Fig. 2) and D. reticulatus (Fig. 3), were found in the city and on the territory of the districts of the region. In urban areas, D. reticulatus was predominant—173 samples. (68%), while D. marginatus was less frequent—81 samples (32%). In the suburban areas of the steppe and forest-steppe, by contrast, D. marginatus was more frequent—265 samples (62%) compared to D. reticulatus—162 samples (38%). In total, 200 ticks of the genus Dermacentor were examined for the presence Babesia-specific DNA. PCR with the subsequent determination of nucleotide sequences showed that in ticks of the species D. reticulatus, 31 samples contained DNA of B. canis. No Babesia DNA was found in ticks of the D. marginatus species. The nucleotide sequences from the tick samples were identical and corresponded to B. canis isolated from ticks in the Novosibirsk region of Southeastern Siberia of Russia (Rar et al., 2006). The sequence of the 18S rRNA gene of B. canis from samples isolated from D. reticulatus ticks (Kaz-Dr93) was first identified in the north region and is available in GenBank under registration number MK070118.1 During the period from 2008 to 2017, there was a pronounced seasonal dynamic of canine babesiosis in the Kostanay region with two peak periods, April–May and September–October (Fig. 4). The largest number of babesiosis diseases in the region falls on September (139.8 ± 52.9) and October (101 ± 35.6). In the remaining months, the number of cases of infection was less, but still quite large in August 78 ± 58.5 dogs, April 56.2 ± 15.9 sick, May 67.9 ± 13.3 dogs, June 35.4 ± 14.2 dogs and July 12.5 ± 6.9 animals. The smallest number of cases was recorded during all the cold months, so in November 2.4 ± 2.9 cases, in December 0.7 ± 1.5, in January 0.4 ± 0.7 dogs, in February and March there were no cases. An important factor for the spread of babesiosis among dogs is the optimal ambient temperature for the development of vector ticks. Figure 5 shows the average monthly temperature fluctuations in the Kostanay region in the period from 2008 to 2017. From Figures 4 and 5 it can be seen that in the examined area during the peak periods of infections, there was an increase in temperature in April (6.8°C ± 2.2°C) and May (14.7°C ± 1.1°C) and a decline in September (12.9°C ± 1.7°C) and October (4.6°C ± 1.7°C). In the hot months from June to August (20.4°C ± 0.19°C), the number of infected dogs with babesiosis decreased, and was only sporadically seen in the cold months from November to December (-10.8°C ± 5.9°C). From February to March, no diseases of dogs with babesiosis were recorded. When analyzing babesiosis among diseased dogs by gender, the number of diseased males slightly exceeds the number of diseased females is 14% higher (Table 2). A tendency of decreased incidence babesiosis with age was also noted (Table 3).
Fig. 1. Seasonal dynamics of ixodid ticks on dogs of Kostanay (the scale means the number of ticks found on 31 dogs). Conditionally, the age susceptibility of dogs can be divided into three age periods, in which there is a significant decrease in the incidence of these animals. The highest rate of infection was detected in dogs up to four years 9.1%–37.3%, while dogs aged 4 to 11 years had infection rates of 2.6%–4.4% and dogs aged 11 to 18 years had the lowest infection rates of 0.2%–1.3%.
Fig. 2. (a) Dermacentor marginatus female; (b) D. marginatus male.
Fig. 3. (a) Dermacentor reticulatus female; (b) D. reticulatus male. Direct microscopic examination of 119 stained blood smears from dogs with symptoms of babesiosis revealed intraeriytocytic and single trophozoites as well as paired pear-shaped merozoites of Babesia sp. “Small” and “large” stages were differentiated by size, shape, the ratio of size to the radius of the erythrocyte, and the localization in the erythrocyte. Microscopy revealed parasites of pear-shape and paired pear-shape, connected by thin ends at sharp (Fig. 6) and right angles (Fig. 7), as well as oval and round (Fig. 8) shapes. The merozoites were equal to or greater than the radius of the erythrocyte, the location in the erythrocyte was in the center. Some parasites were observed in plasma inside smears (Fig. 9) and in neutrophils. The number of Babesia in one erythrocyte varied from 1 to 12. The size of the merozoites inside the erythrocytes was 2.33 - 11.21 × 5.23 - 5.80 μm. Rounded forms of B. canis inside erythrocytes were 2.19 - 4.17 ×2.19 - 4.10 μm; paired pear-shaped 2.19 - 5.77 × 0.87 - 2.90 μm; single pear-shaped forms 2.13 - 5.1 × 1.55 - 2.76 μm; oval 2.38 - 5.93 × 1.46 - 3.95 μm. In all 31 DNA samples from the blood of dogs diagnosed with babesiosis, a fragment of the 18S rRNA gene was amplified. The nucleotide sequence was obtained for 30 samples, in one sample a low luminescence intensity of a specific PCR product was observed. The sequences based on the 394 bp sequence could divided into two haplotypes. Phylogenetic analysis revealed no association of the haplotypes with the year of collection and the place of collection of samples (Fig. 10). Thus, D. reticulatus is widespread in the zone of birch forests—89%, mosaic entering the steppe zone. On the territory of the northern forest-steppe zone, D. reticulates predominates—72%, 28% falls on D. marginatus. D. marginatus dominates in the southern regions of Kostanay region: 80% of the southern forest-steppe zone and 70% of the steppe zone, 20% in the southern forest-steppe zone are D. reticulatus and 30% in the steppe zone.
Fig. 4. Dynamics of the incidence of dogs with babesiosis in Kostanay region.
Fig. 5. Fluctuations in the average monthly temperature in Kostanay region for 2008–2017. Table 2. Incidence of dogs with babesiosis depending on gender.
Table 3. Incidence of dogs with babesiosis depending on age.
DiscussionBabesia canis intraerythrocytic unicellular parasite is a widespread hemoparasite that is transmitted by ixodid ticks and poses a threat to the health and life of dogs all over the world. Several reviews report on the spread of babesiosis in dogs in Europe (Solano-Gallego et al., 2016), in Russia (Livanova et al., 2018; Rar et al., 2005), in the world (Irwin, 2009). The pasture tick D. marginatus is distributed from Portugal, through Southern Europe to Iran and Kazakhstan to the mountainous regions of Central Asia. D. reticulatus also has a wide geographical intersection with D. marginatus from northern Portugal through Kazakhstan and Western Siberia, but usually extends further north than D. marginatus (Rubel et al., 2016; Rubel et al., 2020). A noticeable decrease in cases of infection in dogs with babesiosis in the summer months is associated with an increase in ambient temperature above the optimum (30°С–40°С) for the activity of vector ticks. The activity of ticks is also negatively affected by low ambient temperatures. Babesiosis has a pronounced seasonality, which clearly correlates with the activity of ixodid vector ticks, which, in turn, is consistent with a number of studies from different years, like in France, where the carrier is D. reticulatus, cases of pyroplasmosis were also recorded in spring and autumn, during the period of imago activity of this tick (René-Martellet et al., 2015). During the absence of tick activity (summer and winter), there were also no cases of dogs suffering from piroplasmosis.
Fig. 6. Babesia canis paired pear-shaped.
Fig. 7. (a) Babesia canis paired pear-shaped shape; (b) B. canis paired pear-shaped.
Fig. 8. Babesia canis oval and rounded. According to Kazarina et al. (2000), there are two peaks in the extensiveness of pyroplasmosis invasion in the North Caucasus. In case of unfavorable weather conditions for tick activity (cold winter, dry hot summer) only 20%–25% of the ticks of the subsequent generation are activated, as a result of which there are significantly fewer sick dogs. Makarevich (2018) 51 in his study on the spread of babesiosis in Simferopol wrote that the disease was manifested by two outbreaks of dog morbidity.
Fig. 9. Babesia canis: up to eight merozoites in one erythrocyte. In a study by Loeb (2019), an early manifestation of vector-borne ticks in the United Kingdom is indicated. Similar studies have been published by Hildebrandt et al. (2020) and Schulze et al. (2020). Eisen et al. (2017) in their study, they found that due to changes in weather conditions, the activation of vector-borne ticks, the activation of ixodid ticks occurs earlier in the spring. A similar change was encountered by Johnson et al. (2017), it was revealed on the territory of the USA. Identification of Babesia in ticks showed that in ticks of the species D. reticulatus, 31 samples contained DNA of Babesia belonging to the species B. canis. No Babesia DNA was found in ticks of the D. marginatus species. There is no evidence that ticks of the species D. marginatus are carriers of the parasite B. canis. In a publication by researchers from Italy (Olivieri et al., 2016), B. canis was molecularly characterized in Dermacentor marginatus (but not D. reticulatus) (Rar et al., 2006) and Europe (Zygner et al., 2009; Dwużnik-Szarek et al., 2021; René-Martellet et al., 2015). The analysis of the spread of babesiosis of dogs was carried out in early 2018 according to reports on the disease taken in the State Institution “Veterinary Administration of the Akimat of Kostanay region” for the last 10 years (2008–2017). During this period, 4,943 animals of different ages, sexes, breeds, and conditions of detention were registered with the disease “babesiosis” of dogs. Analysis of the dynamics of the incidence of individuals depending on gender did not reveal a predisposition to the disease babesiosis, the susceptibility of animals was on average the same. However, males were more predisposed to the disease (57% of susceptible males and 43% of females). The ratio of males to the number of females admitted to the reception was 1:1.6. This indicator is similar to the data of Kosheleva and Molchanov (2006).
Fig. 10. A phylogenetic tree. Among the animals analyzed for babesiosis, the highest proportion is found in the age range of 1 to 4 years (72%), followed by 4–11 years (25%), while the lowest number of dogs falls in the age group of 11–18 years (3%). The least susceptibility was found in animals at the age of 12 years. With age, the susceptibility of dogs to babesiosis decreases. It may also be because the body develops more immunity when reinfected. According to Kazakh and foreign authors, the incidence of babesiosis in dogs varies with age. Puppies under three months rarely get sick, while the highest rates are seen in dogs between one and three years old. Prevalence decreases slightly in older age groups (Kosheleva and Molchanov, 2006; Egorov et al., 2015). The author explains this phenomenon by the lack of contact of animals at this age with vector ticks, and not by age-related immunity. Historically, Babesia spp. in dogs was detected by their morphological appearance in erythrocytes of blood smears (Böhm et al., 2006). In veterinary clinics of the Kostanay region, the diagnosis of babesiosis in dogs is made on the basis of light microscopy of thin smears taken from the ear vein. According to the results of a veterinary examination of 119 dogs, 31 dogs with clinical signs of babesiosis (fever, hemoglobinuria, mucosal jaundice, lethargy) had Babesia in 31 blood smears during hemoscopy. The description of morphology is generally similar to the studies by D. Huber et al. (2017), Kosheleva and Molchanov (2006), and L. Solano-Gallego et al. (2016). The conducted molecular analysis of the blood sample of dogs revealed the presence of the species B. canis. The results of this study give an idea of the distribution of B. canis haplotype in dogs in the Kostanay region. The existence of the subspecies of B. canis is consistent with other studies in the border zones with Russia and expands the data on the distribution of B. canis (Rar et al., 2005, 2006). The main ticks attacking dogs in the Kostanay region are meadow ticks D. reticulatus. Ticks of D. reticulatus are well-known as specific vectors of B. canis, at the same time pasture ticks of D. marginatus have not shown the ability to transfer pathogens of babesiosis of dogs (Solano-Gallego et al., 2016). In conclusion, the results of microscopic and molecular studies of the blood of dogs and ixodid ticks of the species D. reticulatus demonstrate the presence of B. canis in the northern region of Kazakhstan. ConclusionIxodid ticks of the genus Dermacentor have been registered in the territory of the Kostanay region with two species D. reticulatus, D. marginatus. Of these, one species has been identified on dogs, which serves as a carrier of babesiosis of dogs—D. reticulatus. The epizootiological monitoring of Babesia infestation among dogs in the Kostanay region and the city of Kostanay from 2008 to 2017 revealed several key findings. Babesiosis in dogs was found to occur throughout all seasons, but it exhibited a distinct seasonal pattern with two peak periods: April–May and September–October. Both male and female dogs were equally susceptible to babesiosis, although there was a slight predominance of the disease in males (7%). The majority of cases occurred in dogs before the age of one year (37.3%), and there was a decreasing trend in susceptibility to babesiosis with age. The findings from the epizootiological monitoring highlighted that the problem of combating babesiosis in the Kostanay region and city was still unresolved. Therefore, it is crucial to develop preventive measures to effectively reduce the incidence of babesiosis in dogs. Furthermore, this study provided the first evidence in the northern region of Kazakhstan regarding the specific type of Babesia parasite present in the blood of dogs and ticks. It was determined that B. canis was the primary causative agent of babesiosis in dogs in the Kostanay region. The genetic variants of B. canis identified in the dog blood samples were consistent with those previously reported in Europe and Russia. To identify the different strains of Babesia, the researchers employed nucleotide sequencing of the 18S rRNA gene fragment and compared the sequences to establish nucleotide identity, resulting in the identification of 31 Babesia strains. AcknowledgmentsNone. Conflict of interestThe authors declared no potential conflicts of interest with respect to the research, authorship, and/or publication of this article. Authors’ contributionAll of the authors contributed to the study. Also, all of the authors read and approved the final version of manuscript. FundingThis research received no specific grant. Data availabilityAll data supporting the findings of this study are available within the manuscript. ReferencesBaneth, G., Cardoso, L., Brilhante-Simões, P. and Schnittger, L. 2019. Establishment of Babesia vulpes n. sp. (Apicomplexa: Babesiidae), a piroplasmid species pathogenic for domestic dogs. Parasit. Vect. 12, 129. Belimenko, V.V., Zabolotsky, V.T., Sarukhanyan, A.R. and Khristianovsky, P.I. 2012. Babesiosis of dogs. Rus. Vet. J. 2, 42–46. Böhm, M., Leisewitz, A.L., Thompson, P.N. and Schoeman, J.P. 2006. Capillary and venous Babesia canis rossi parasitaemias and their association with outcome of infection and circulatory compromise. Vet. Parasitol. 141, 18–29. Boozer, A.L. and Macintire, D.K. 2003. Canine babesiosis. Vet. Clin. North Am. Small Anim. Pract. 33(4), 885–904. Cacciò, S.M., Antunovi, B., Moretti, A., Mangili, V., Marinculic, A., Baric, R.R., Slemenda, S.B. and Pieniazek, N.J. 2002. Molecular characterisation of Babesia canis canis and Babesia canis vogeli from naturally infected European dogs. Vet. Parasitol. 106(4), 285–292. Camacho, A.T., Guitian, F.J., Pallas, E., Gestal, J.J., Olmeda, S., Goethert, H., Telford 3rd, S. and Spielman, A. 2005. Serum protein response and renal failure in canine Babesia annae infection. Vet. Res. 36(5–6), 713–722. Clancey, N., Horney, B., Burton, S., Birkenheuer, A., McBurney, S. and Tefft, K. 2010. Babesia (Theileria) annae in a red fox (Vulpes vulpes) from Prince Edward Island, Canada. J. Wildl. Dis. 46(2), 615–621. del Mar Fernández de Marco, M., Hernández-Triana, L.M., Philipps, L.P., Hansford, K., Mitchell, E.S., Cull, B., Swainsbury, C.S., Fooks, A.R., Medlock, J.M. and Johnson, N. 2017. Emergence of Babesia canis in Southern England. Parasit. Vector. 10, 241. Domatsky, V.N. and Aubakirov, M.J. 2015. Parasitic insects and ticks. Kostanay: KSU named after A.Baitursynov. Duh, D., Tozon, N., Petrovec, M., Strasek, K. and Avsic-Zupanc, T. 2004. Canine babesiosis in Slovenia: molecular evidence of Babesia canis canis and Babesia canis vogeli. Vet. Res. 35, 363–368. Dwużnik-Szarek, D., Mierzejewska, E.J., Rodo, A., Goździk, K., Behnke-Borowczyk, J., Kiewra, D., Kartawik, N. and Bajer, A. 2021. Monitoring the expansion of Dermacentor reticulatus and occurrence of canine babesiosis in Poland in 2016–2018. Parasit. Vect. 14, 267. Egorov, D.S., Balandina, V.N., Kryuchkova, E.N., Kuzmichev, V.V. and Egorov, S.V. 2015. Babesiosis of dogs in the upper Volga region. In Materials of the scientific and practical conference of the Ivanovo State Agricultural Academy, pp. 54–56. Eisen, L., Breuner, N.E., Hojgaard, A., Hoxmeier, J.C., Pilgard, M.A., Replogle, A.J., Biggerstaff, B.J. and Dolan, M.C. 2017. Comparison of vector efficiency of Ixodes scapularis (Acari: Ixodidae) from the Northeast and Upper Midwest of the United States for the Lyme Disease spirochete Borrelia mayonii. J. Med. Entomol. 54(1), 239–242. Hildebrandt, A., Franke, J., Schmoock, G., Pauliks, K., Krämer, A. and Straube, E. 2020. Diversity and coexistence of tick-borne pathogens in Central Germany. J. Med. Entomol. 48(3), 651–655. Hilpertshauser, H., Deplazes, P., Meli, M.L., Hofmann-Lehmann, R., Lutz, H. and Mathis, A. 2007. Genotyping of Babesia bigemina from cattle from a non-endemic area (Switzerland). Vet. Parasitol. 145, 59–64. Huber, D., Beck, A., Anzulović, Ž., Jurković, D., Polkinghorne, A., Baneth, G. and Beck, R. 2017. Microscopic and molecular analysis of Babesia canis in archived and diagnostic specimens reveal the impact of antiparasitic treatment and postmortem changes on pathogen detection. Parasit. Vect. 10(1), 495. Irwin, P.J. 2009. Canine babesiosis: from molecular taxonomy to control from 4th International Canine Vector-Borne Disease Symposium Seville, Spain. Parasit. Vect. 2, 54–58. Johnson, T.L., Graham, C.B., Boegler, K.A., Cherry, C.C., Maes, S.E., Pilgard, M.A., Hojgaard, A., Buttke, D.E. and Eisen, R.J. 2017. Prevalence and diversity of tick-borne pathogens in nymphal Ixodes scapularis (Acari: Ixodidae) in Eastern National Parks. J. Med. Entomol. 54(3), 742–751. Kazarina, E.V., Dyachenko, Y.V. and Lutsuk, S.N. 2000. Epizootic situation of pyroplasmosis of dogs in Stavropol. In Collection of Scientific Conference “Diagnostics, treatment and prevention of diseases of farm animals”, pp: 78–81. Kosheleva, M.I. and Molchanov, I.A. 2006. Babesiosis of dogs: epizootology, morphometry of the parasite, phagocytic activity of neutrophils depending on the severity of the course of invasion. Vet. Pathol. 3(18), 31–37. Köster, L.S., Lobetti, R.G. and Kelly, P. 2015. Canine babesiosis: a perspective on clinical complications, biomarkers, and treatment. Vet. Med. 6, 119–128. Kumar, S., Tamura, K. and Nei, M. 2004. MEGA3: integrated software for molecular evolutionary genetics analysis and sequence alignment. Brief. Bioinform. 5(2), 150–163. Lack, J.B., Reichard, M.V. and Van Den Bussche, R.A. 2012. Phylogeny and evolution of the Piroplasmida as inferred from 18S rRNA sequences. Int. J. Parasitol. 42(4), 353–363. Livanova, N.N., Fomenko, N.V., Akimov, I.A., Ivanov, M.J., Tikunova, N.V., Armstrong, R. and Konyaev, S.V. 2018. Dog survey in Russian veterinary hospitals: tick identification and molecular detection of tick-borne pathogens. Parasit. Vect. 11, 591. Loeb, J. 2019. TBE virus has arrived in the UK. Vet. Rec. 185(18), 558–559. Makarevich, N.A. 2018. Piroplasmosis of dogs, epizootology, treatment and prevention. In: Agrobiological foundations of sensory-landscape management of agricultural production, pp. 209–211. Malkova, M.G. 2011. Changing the boundaries of the ranges of pasture ixodid mites on the territory of Western Siberia: possible causes and consequences. In All-Russian conference with international participation “Modern aspects of natural foci of diseases”, pp: 55–56. Olivieri, E., Zanzani, S.A., Latrofa, M.S., Lia, R.P., Dantas-Torres, F., Otranto, D., and Manfredi, M.T. 2016. The southernmost foci of Dermacentor reticulatus in Italy and associated Babesia canis infection in dogs. Parasit. Vect. 9, 213. Rar, V.A., Bolyakhina, S.A., Zakharenko, L.P. and Astanin, V.P. 2006. Babesia canis canis is the main infectious agent of babesiosis of dogs in the Novosibirsk region. Rus. Vet. J. 2, 14–16. Rar, V.A., Maksimova, T.G., Zakharenko, L.P., Bolykhina, S.A., Dobrotvoesky, A.K. and Morozova, O.V. 2005. Babesia DNA detection in canine blood and Dermacentor reticulatus ticks in Southwestern Siberia, Russia. Vector Borne Zoonotic Dis. 5(3), 285–287. René-Martellet, M., Moro, C.V., Chêne, J., Bourdoiseau, G., Chabanne, L. and Mavingui, P. 2015. Update on epidemiology of canine babesiosis in Southern France. BMC Vet. Res. 11, 223. Rubel, F., Brugger, K., Belova, O.A., Kholodilov, I.S., Didyk, Y.M., Kurzrock, L., García-Pérez, A.L. and Kahl, O. 2020. Vectors of disease at the northern distribution limit of the genus Dermacentor in Eurasia: D. reticulatus and D. silvarum. Exp. Appl. Acarol. 82, 95–123. Rubel, F., Brugger, K., Pfeffer, M., Chitimia-Dobler, L., Didyk, Y.M., Leverenz, S., Dautel, H. and Kahl, O. 2016. Geographical distribution of Dermacentor marginatus and Dermacentor reticulatus in Europe. Ticks Tick Borne Dis. 7(1), 224–233. Schnittger, L., Rodriguez, A.E., Florin-Christensen, M. and Morrison, D.A. 2012. Babesia: a world emerging. Infect. Genet. Evol. 12(8), 1788–1809. Schulze, T., Jordan, R., Healy, S. and Roegner, V. 2020. Detection of Babesia microti and Borrelia burgdorferi in host-seeking Ixodes scapularis (Acari: Ixodidae) in Monmouth County, New Jersey. J. Med. Entomol. 50(2), 379–383. Shabdarbayeva, G.S. and Balgimbayeva, A.I. 2008. Ixodofauna and features of epizootology of pyroplasmosis of dogs in the South-East of Kazakhstan. In Mathematic Scientific and Practical Conference “Innovations in the Agricultural Sector of Kazakhstan”, pp: 575–581. Shabdarbayeva, G.S. and Balgimbayeva, A.I. 2011. The state of diagnostics of blood parasitic diseases of animals. In Proceedings of the National Academy of Sciences of the Republic of Kazakhstan, pp. 11–17. Solano-Gallego, L. and Baneth, G. 2011. Babesiosis in dogs and cats expanding parasitological and clinical spectra. Vet. Parasitol. 181, 48–60. Solano-Gallego, L., Sainz, Á., Roura, X., Estrada-Peña, A., Miró, G. 2016. A review of canine babesiosis: the European perspective. Parasit. Vect. 9, 336. Yeagley, T.J., Reichard, M.V., Hempstead, J.E., Allen, K.E., Parsons, L.M. and White, M.A. 2009. Detection of Babesia gibsoni and the canine small Babesia “Spanish isolate” in blood samples obtained from dogs confiscated from dogfighting operations. J. Am. Vet. Med. Assoc. 235(5), 535–539. Zahler, M., Rinder, H. and Schein, E. 2000. Detection of a new pathogenic Babesia microti—like species in dogs. Vet. Parasitol. 89(3), 241–248. Zygner, W., Górski, P. and Wedrychowicz, H. 2009. New localities of Dermacentor reticulatus tick (vector of Babesia canis canis) in central and eastern Poland. Pol. J. Vet. Sci. 12(4), 549–555. | ||
| How to Cite this Article |
| Pubmed Style Zhabykpayeva A, Kulakova L, Rychshanova R, Suleimanova K, Shevtsov A. Identification of the causative agent of canine babesiosis in the North of Kazakhstan. Open Vet. J.. 2023; 13(9): 1184-1194. doi:10.5455/OVJ.2023.v13.i9.14 Web Style Zhabykpayeva A, Kulakova L, Rychshanova R, Suleimanova K, Shevtsov A. Identification of the causative agent of canine babesiosis in the North of Kazakhstan. https://www.openveterinaryjournal.com/?mno=151683 [Access: January 25, 2026]. doi:10.5455/OVJ.2023.v13.i9.14 AMA (American Medical Association) Style Zhabykpayeva A, Kulakova L, Rychshanova R, Suleimanova K, Shevtsov A. Identification of the causative agent of canine babesiosis in the North of Kazakhstan. Open Vet. J.. 2023; 13(9): 1184-1194. doi:10.5455/OVJ.2023.v13.i9.14 Vancouver/ICMJE Style Zhabykpayeva A, Kulakova L, Rychshanova R, Suleimanova K, Shevtsov A. Identification of the causative agent of canine babesiosis in the North of Kazakhstan. Open Vet. J.. (2023), [cited January 25, 2026]; 13(9): 1184-1194. doi:10.5455/OVJ.2023.v13.i9.14 Harvard Style Zhabykpayeva, A., Kulakova, . L., Rychshanova, . R., Suleimanova, . K. & Shevtsov, . A. (2023) Identification of the causative agent of canine babesiosis in the North of Kazakhstan. Open Vet. J., 13 (9), 1184-1194. doi:10.5455/OVJ.2023.v13.i9.14 Turabian Style Zhabykpayeva, Aigul, Lyubov Kulakova, Raushan Rychshanova, Kulyay Suleimanova, and Alexandr Shevtsov. 2023. Identification of the causative agent of canine babesiosis in the North of Kazakhstan. Open Veterinary Journal, 13 (9), 1184-1194. doi:10.5455/OVJ.2023.v13.i9.14 Chicago Style Zhabykpayeva, Aigul, Lyubov Kulakova, Raushan Rychshanova, Kulyay Suleimanova, and Alexandr Shevtsov. "Identification of the causative agent of canine babesiosis in the North of Kazakhstan." Open Veterinary Journal 13 (2023), 1184-1194. doi:10.5455/OVJ.2023.v13.i9.14 MLA (The Modern Language Association) Style Zhabykpayeva, Aigul, Lyubov Kulakova, Raushan Rychshanova, Kulyay Suleimanova, and Alexandr Shevtsov. "Identification of the causative agent of canine babesiosis in the North of Kazakhstan." Open Veterinary Journal 13.9 (2023), 1184-1194. Print. doi:10.5455/OVJ.2023.v13.i9.14 APA (American Psychological Association) Style Zhabykpayeva, A., Kulakova, . L., Rychshanova, . R., Suleimanova, . K. & Shevtsov, . A. (2023) Identification of the causative agent of canine babesiosis in the North of Kazakhstan. Open Veterinary Journal, 13 (9), 1184-1194. doi:10.5455/OVJ.2023.v13.i9.14 |